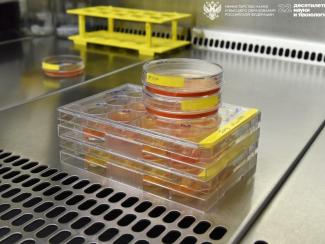
Новый способ оценки эффективности терапии рака предложили ученые

Достижения науки
20 ноября
19 ноября
Технологии для геномной медицины
Новосибирская компания ведет разработку ферментов для подготовки NGS-библиотек
18 ноября
17 ноября
Проверка нейросети
Сотрудники НГУ создали фреймворк для управления моделями искусственного интеллекта
12 ноября
Высокочувствительные биосенсоры и материалы для гибкой электроники
В Новосибирске прошла Школа молодых ученых «АППН-2025»
11 ноября
Две цели сразу
Ученые разрабатывают уникальный отечественный препарат от сахарного диабета второго типа
10 ноября
07 ноября
"Термоглаза" для врачей, датчики для двигателей
В Академпарке представили новейшие разработки стартапов
05 ноября
Автономный "Коммандор"
В НГУ разработали голосовой интерфейс для «умного дома», защищенный от взломов
Страницы
- 1
- 2
- 3
- 4
- 5
- 6
- 7
- 8
- 9
- …
- следующая ›
- последняя »